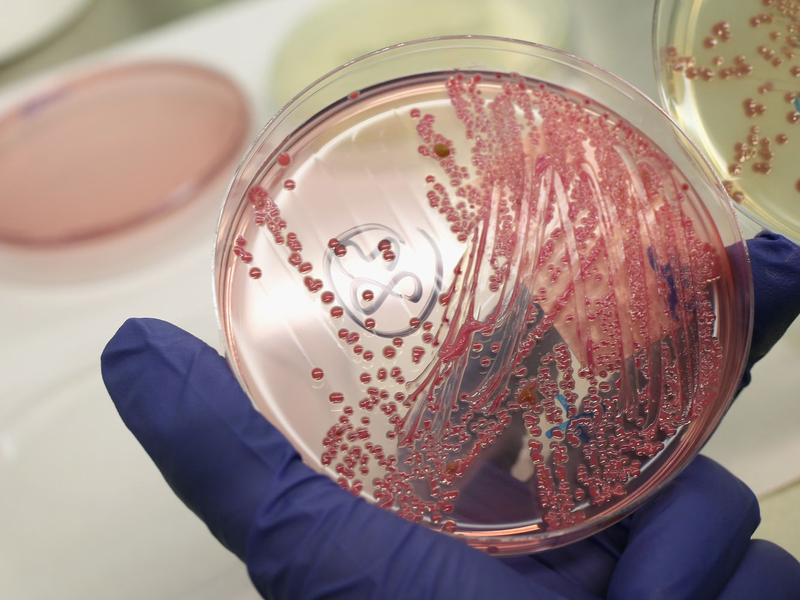
Thắc mắc thường gặp: Vi khuẩn ăn thịt người có lây không? 3

Dược sĩ Đại học có nhiều năm kinh nghiệm trong việc tư vấn Dược phẩm và hỗ trợ giải đáp thắc mắc về Bệnh học. Hiện đang là giảng viên cho Dược sĩ tại Nhà thuốc Long Châu.
Kim Ngân
01/06/2024
Mặc định
Lớn hơn
"Vi khuẩn ăn thịt người có lây không?" là câu hỏi hoang mang của nhiều người khi hiện nay bệnh có xu hướng phát triển ngày càng mạnh mẽ và để lại nhiều biến chứng nguy hiểm, thậm chí tỷ lệ tử vong rất cao nếu không phát hiện kịp thời.
Bệnh "vi khuẩn ăn thịt người" là tình trạng miêu tả bản chất của loại vi khuẩn gây ra tình trạng viêm cân mạc hoại tử (Whitmore). Bệnh này do loại vi khuẩn B.pseudomallei có trong môi trường đất và xâm nhập vào cơ thể qua các vết thương hở, nếu mắc bệnh sẽ kèm theo nhiều biến chứng khó lường và nguy cơ tử vong rất cao chỉ trong 48 giờ. Chính vì thế việc chủ động phòng ngừa phù hợp là hoàn toàn cần thiết ở thời điểm hiện nay, đặc biệt đối với những người có tiền sử bệnh nền thì sẽ càng có nguy cơ cao mắc bệnh. Tuy nhiên trước tiên chúng ta cần phải tìm hiểu về các thông tin về căn bệnh này như vi khuẩn ăn thịt người có lây không, tất cả sẽ có trong bài viết sau đây của Nhà thuốc Long Châu, mời mọi người xem qua nhé!
Bệnh vi khuẩn ăn thịt người hay còn gọi là viêm cân mạc hoại tử do nhiều loại vi khuẩn gây ra, điển hình là liên cầu khuẩn beta tan huyết trong nhóm A, tụ cầu vàng, vibrio vulnificus, clostridium,…

Nhắc đến bệnh vi khuẩn ăn thịt người thì hầu hết các trường hợp mắc bệnh đều do liên cầu khuẩn beta nhóm A gram dương gây ra. Chúng tập trung với nhau thành cụm hình tròn, có màu sắc trong suốt hoặc mờ đục với nhiều hồng cầu bị phá vỡ tập trung xung quanh cụm này.
Vi khuẩn tụ cầu vàng cũng thuộc nhóm vi khuẩn gram dương, có họ Staphylococcaceae và hình dạng tròn màu vàng đậm, màu trắng hoặc màu cam.
Vibrio vulnificus thuộc nhóm vi khuẩn gram âm nổi tiếng gây ra các bệnh nhiễm trùng đường ruột với triệu chứng tiêu chảy nghiêm trọng, chúng sinh trưởng trong vùng nước 200 độ C trở lên. Bên cạnh hiện tượng viêm cân mạc hoại tử thì chúng còn gây ra các bệnh nhiễm khuẩn khi chúng ta ăn các loại hải sản (đặc biệt là hàu sống) không được chế biến đảm bảo vệ sinh, với tỷ lệ tử vong lên đến 50%.
Vi khuẩn Klebsiella có thể gây ra các bệnh từ ruột và lan sang các bộ phận khác, các bệnh do vi khuẩn Klebsiella gây ra có thể kể đến như nhiễm trùng máu, viêm màng não,... Đặc biệt chúng ngày càng phát triển và có thể kháng lại thuốc kháng sinh.
Hiện tượng viêm cân mạc hoại tử do vi khuẩn ăn thịt người gây ra được chia thành 2 dạng:
Theo thống kê mỗi năm tại Hoa Kỳ thì trung bình có đến 700 ca bệnh chẩn đoán mắc viêm cân mạc hoại tử và tỷ lệ tử vong cao đến 30%.

Vi khuẩn burkholderia pseudomallei gây ra bệnh Whitmore xâm nhập vào cơ thể con người thông qua các vết thương hở như vết trầy xước, côn trùng cắn,... hoặc các vết thương trong hoặc sau phẫu thuật (trường hợp rất hiếm). Thêm nữa vi khuẩn còn xâm nhập qua đường hô hấp khi chúng ta hít phải bụi, nước mưa chứa vi khuẩn và kèm theo nhiều biến chứng nguy hiểm như suy đa tạng, sốc nhiễm khuẩn và tử vong rất nhanh chóng.
Trước nguy cơ bùng phát ngày càng mạnh mẽ của loại vi khuẩn ăn thịt người thì nhiều người cũng bắt đầu có sự chủ động tìm hiểu các thông tin về căn bệnh nguy hiểm này, trong đó điển hình là thắc mắc vi khuẩn ăn thịt người có lây không.
Câu trả lời là Whitmore không phải bệnh phổ biến và khó lây lan thành dịch, tuy vậy mỗi năm vẫn ghi nhận nhiều ca mắc bệnh từ tháng 9 - 10, rơi vào các đợt mưa lũ, vì chúng thường sinh sôi phát triển trong môi trường nước, đất bị ô nhiễm, số ít do ăn uống các thực phẩm ô nhiễm và rất ít ca mắc bệnh do lây từ người sang người.
Qua đó khi nghi ngờ bản thân mắc bệnh và để chẩn đoán tình trạng bệnh thì người bệnh cần phải thực hiện một số xét nghiệm để có kết luận chính xác nhất.
Vi khuẩn gây bệnh vi khuẩn ăn thịt người (viêm cân mạc hoại tử) phát triển rất nhanh, do đó để chẩn đoán xác định bệnh Whitmore thì đầu tiên bác sĩ sẽ dựa vào biểu hiện lâm sàng, nhất là giai đoạn cấp tính như có chấn thương hoặc xây xước da hay không.
Sau đó bệnh nhân sẽ được chỉ định tiến hành thực hiện một số xét nghiệm trong nước tiểu, đờm, trong máu hoặc tại vùng da tổn thương như dưới đây:
Khi nghi ngờ mắc bệnh Whitmore và thực hiện chụp X-quang sẽ phát hiện những tổn thương trên phim, cụ thể là tổn thương hoại tử phổi, tràn dịch màng phổi,... cùng nhiều dấu hiệu thường gặp khác.
Chụp cắt lớp CT để xác định vị trí tổn thương áp xe không có triệu chứng ở lá lách, gan, thận,... do nhiễm khuẩn gây ra.
Xét nghiệm máu là cách chẩn đoán xác định rõ sự thay đổi của bạch cầu do cơ thể bị nhiễm khuẩn, tuy vậy nếu xét nghiệm máu âm tính thì vẫn phải thực hiện thêm các xét nghiệm khác để loại trừ khả năng mắc bệnh Whitmore.
Thiết sinh mô là phương pháp lấy mẫu đại diện vùng da bị nhiễm trùng để xác định vi khuẩn gây bệnh và có phương án điều trị phù hợp.
Bài viết trên đây đã có những chia sẻ đến bạn đọc một số thông tin về căn bệnh do vi khuẩn ăn thịt người gây ra, từ đó mọi người sẽ có câu trả lời về việc vi khuẩn ăn thịt người có lây không, cách chẩn đoán và phòng ngừa bệnh tối ưu nhất là gì trước diễn biến phức tạp của loại vi khuẩn nguy hiểm này.
Xem thêm:
Dược sĩ Đại họcNguyễn Mỹ Huyền
Dược sĩ Đại học có nhiều năm kinh nghiệm trong việc tư vấn Dược phẩm và hỗ trợ giải đáp thắc mắc về Bệnh học. Hiện đang là giảng viên cho Dược sĩ tại Nhà thuốc Long Châu.